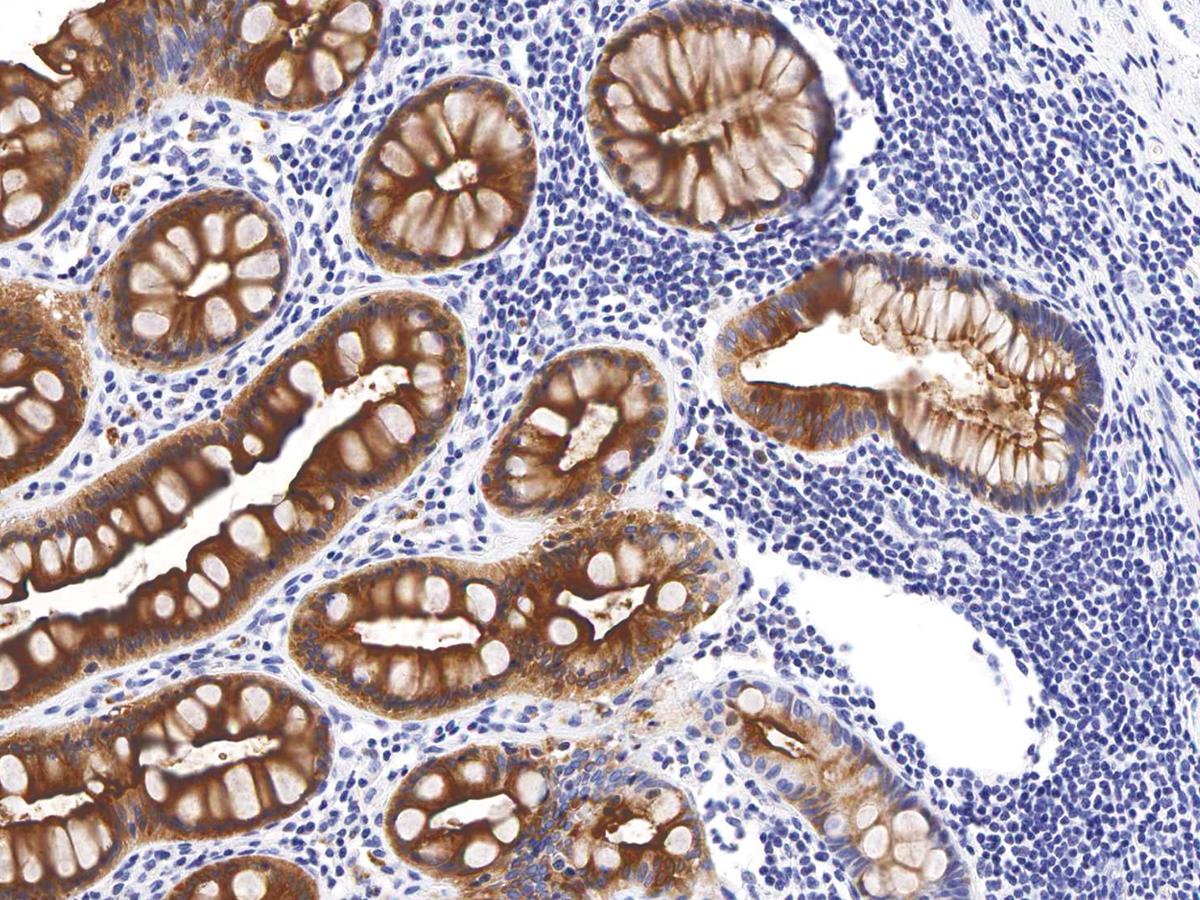

Anti-CEA Monoclonal Antibody (Clone:IHC543)-Ready to Use
Shipping Info:
For estimated delivery dates, please contact us at [email protected]
| Format : | Predilute |
| Amount : | 7 ml |
| Purification : | Protein A/G Chromatography |
| Storage condition : | Store at 2°C - 8°C. |
Carcinoembryonic antigen (CEA) describes a set of glycophosphatidyl inositol and transmembrane cell-surface-anchored glycoproteins involved in cell adhesion, differentiation, anoikis, polarization, and tissue architecture. CEA staining, along with Calretinin, CK 5/6, D2-40, HBME-1, Napsin A, MOC-31, and Ber-EP4, is used to help differentiate between adenocarcinoma and mesothelioma. Staining with Anti-CEA is also suggested to be useful in identifying the origin of metastatic adenocarcinoma. CEA is an effective marker for adenocarcinomas of the lung, colon, stomach, esophagus, pancreas, gallbadder, urachus, salivary gland, ovary, and endocervix.
This product is available in ready to use format, hence no dilution is required.
For Research Use Only. Not for use in diagnostic/therapeutics procedures.
|
There are currently no product reviews
|

.png)











